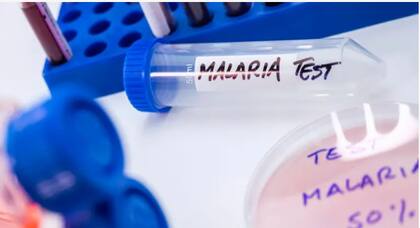
El olor de una persona puede revelar si se ha contagiado de malaria

Un olor novedoso puede indicar que algo cambió o que algo va mal en el organismo; las claves y los avances de la tecnología en este campo
11 minutos de lectura'

Obviamente era una tontería. Así reaccionó la química analítica Perdita Barran cuando un compañero le habló de una mujer escocesa que aseguraba que podía oler la enfermedad de Parkinson. “Probablemente solo huele a personas mayores y reconoce los síntomas del Parkinson y establece alguna asociación”, recuerda haber pensado Barran.
La mujer, una enfermera jubilada de 74 años llamada Joy Milne, se había acercado al colega de Barran, Tilo Kunath, neurocientífico de la Universidad de Edimburgo, en 2012 en un evento en el que él daba una charla.
Milne le contó a Kunath que había descubierto su habilidad después de notar que su marido, Les, había desarrollado un nuevo olor almizclado años atrás. Más tarde le diagnosticaron la enfermedad de Parkinson, una enfermedad neurodegenerativa progresiva caracterizada por temblores y otros síntomas motores.
Fue cuando Milne asistió a una reunión de grupo para pacientes de Parkinson en su ciudad natal, Perth, Escocia, cuando estableció la conexión: todos los pacientes tenían el mismo olor almizclado. “Así que decidimos comprobar si tenía razón”, dice Barran, que en ese momento trabajaba en la Universidad de Edimburgo, pero ahora está en la Universidad de Manchester.
Resultó que Milne no era una persona que les haría perder el tiempo. Kunath, Barran y sus colegas le pidieron a Milne que oliera 12 camisetas, seis de las cuales habían sido usadas recientemente por pacientes con Parkinson, junto con otras seis usadas por personas que no padecían la enfermedad.
Ella identificó correctamente a los seis pacientes. Es más, identificó a otra persona que menos de un año después fue diagnosticada con Parkinson.
“Fue algo increíble”, dice Barran. “Ella diagnosticó la enfermedad de antemano, tal y como había hecho con su marido”. En 2015, la noticia de su asombrosa habilidad fue portada en los medios de comunicación de todo el mundo.
El olor de las enfermedades
La historia de Milne no es tan descabellada como podría parecer. El cuerpo humano desprende una gran variedad de olores. Un olor nuevo puede indicar que algo ha cambiado o que algo va mal en el organismo.
Ahora, los científicos están trabajando en técnicas para detectar sistemáticamente biomarcadores olfativos que podrían acelerar el diagnóstico de una amplia gama de enfermedades, desde el Parkinson y las lesiones cerebrales hasta el cáncer. La clave para detectarlos podría estar justo frente a nuestras narices.

“Me parece una locura que haya gente muriendo y que estemos pinchando el trasero a personas con agujas para averiguar si tienen cáncer de próstata, cuando la señal ya está fuera y es detectable por los perros”, afirma Andreas Mershin, físico y cofundador de RealNose.ai, una empresa que está desarrollando una nariz robótica para diagnosticar enfermedades basándose en el olfato.
Esta tecnología es necesaria, ya que relativamente pocas personas tienen un olfato lo suficientemente potente como para detectar estas sustancias bioquímicas reveladoras que aparecen en las primeras etapas de una enfermedad.
Joy Milne, resultó ser una de esas pocas personas. Tiene hiperosmia hereditaria, un rasgo que significa que su sentido del olfato es mucho más sensible que el de la media de los seres humanos, es decir, tiene un olfato superdesarrollado.
Hay algunas enfermedades que desprenden un olor tan característico que la mayoría de los seres humanos pueden olerlas.
El aliento o la piel de las personas con diabetes que sufren un episodio hipoglucémico, por ejemplo, pueden tener un aroma afrutado o a “manzanas podridas” debido a la acumulación en el torrente sanguíneo de sustancias químicas ácidas de olor afrutado llamadas cetonas. Estas se producen cuando el cuerpo metaboliza la grasa en lugar de la glucosa.
Las personas con enfermedades hepáticas pueden desprender un olor a humedad o azufre en el aliento o la orina, mientras que si el aliento huele a amoníaco o tiene un aroma “a pescado” o “a orina”, podría ser un signo de enfermedad renal.

Algunas enfermedades infecciosas también desprenden olores característicos. Las heces con olor dulce podrían ser un signo de infección por cólera o por la bacteria Clostridioides difficile, que es una causa común de diarrea, aunque un estudio descubrió que un grupo de desafortunadas enfermeras de hospital no pudieron diagnosticar con precisión a los pacientes olfateando sus heces.
Por su parte, la tuberculosis puede hacer que el aliento de una persona huela mal, como a cerveza rancia, y que su piel huela a cartón marrón mojado y salmuera. Sin embargo, para detectar otras enfermedades se necesita un tipo de olfato especial.
Los perros, por ejemplo, tienen un sentido del olfato que, según se dice, es hasta 100.000 veces más potente que el nuestro. Los científicos han entrenado a los caninos para detectar cánceres de pulmón, mama, ovario, vejiga y próstata en las personas.
En un estudio sobre el cáncer de próstata, por ejemplo, los perros fueron capaces de detectar la enfermedad en muestras de orina con una tasa de éxito del 99%. También se ha entrenado a los perros para detectar los primeros signos de la enfermedad de Parkinson, la diabetes, las crisis epilépticas inminentes y la malaria, todo ello solo mediante el olfato.
Pero no todos los perros tienen lo que se necesita para convertirse en detectores de enfermedades, y se requiere tiempo para entrenar a los animales que sí lo tienen.
Algunos científicos afirman que podemos replicar en un laboratorio las asombrosas capacidades olfativas de los caninos, y personas como Milne, y tal vez ofrecer la posibilidad de realizar un simple frotis que podría enviarse para ser analizado análisis.
Barran, por ejemplo, está utilizando la cromatografía de gases y la espectrometría de masas para analizar el sebo (una sustancia grasa que se produce en la piel de las personas) de pacientes con Parkinson.
La cromatografía de gases separa los compuestos y la espectrometría de masas los pesa, lo que permite determinar la naturaleza precisa de las moléculas presentes. Las industrias alimentarias, de bebidas y de perfumería ya utilizan habitualmente esta forma de análisis de olores.
Pruebas rápidas
De los aproximadamente 25.000 compuestos que se encuentran habitualmente en la piel humana, unos 3.000 se regulan de forma diferente en las personas con Parkinson, señala Barran.
“Ahora nos encontramos en una situación en la que hemos reducido esa cifra a unos 30 que son realmente diferentes de forma sistemática en todas las personas con Parkinson”, indica. Muchos de los compuestos son lípidos, o grasas, y ácidos grasos de cadena larga, afirma.

Por ejemplo, un estudio inicial se centró en tres moléculas similares a los lípidos relacionadas con el olor causado por la enfermedad: el ácido hipúrico, el eicosano y el octadecanal. Esto tiene sentido, ya que estudios anteriores sugieren que el metabolismo lipídico anormal es un rasgo característico de la enfermedad de Parkinson.
“Lo que hemos descubierto es que la capacidad de las células para transportar ácidos grasos de cadena larga a las mitocondrias se ve afectada [en las personas con enfermedad de Parkinson]”, afirma Barran. “Por lo tanto, sabemos que hay más lípidos de este tipo circulando por el cuerpo, y algunos de ellos se excretan a través de la piel, y eso es lo que medimos”.
El equipo está desarrollando ahora una sencilla prueba con un hisopo cutáneo que permite detectar la enfermedad de Parkinson en sus primeras fases. Actualmente, los médicos de cabecera suelen derivar a las personas que presentan síntomas similares a temblores a un neurólogo, que se encarga de realizar el diagnóstico. Sin embargo, esto puede llevar años.
“Lo que queremos es disponer de una prueba muy rápida y no invasiva que permita clasificar eficazmente a los pacientes, de modo que puedan acudir a un neurólogo que los evalúe y les diga “sí” o “no”, afirma Barran.
El rol de las moléculas
Pero, ¿por qué las enfermedades afectan al olor corporal? La razón se debe a un grupo de moléculas conocidas como compuestos orgánicos volátiles (COV).
Para mantenerse con vida, nuestro cuerpo debe convertir continuamente los alimentos y las bebidas en energía. Lo hace a través de una serie de reacciones químicas que tienen lugar dentro de las mitocondrias, las diminutas estructuras de nuestras células que convierten los azúcares de los alimentos en energía que nuestro cuerpo puede utilizar.
Estas reacciones químicas producen moléculas conocidas como metabolitos, algunos de los cuales son volátiles, lo que significa que se evaporan fácilmente a temperatura ambiente y, por lo tanto, pueden ser percibidos por nuestro olfato. Los COV son luego excretados por el cuerpo.

En 2016, publicaron un estudio en el que revelaban que las lesiones cerebrales traumáticas en ratones provocan un olor distintivo y que es posible entrenar a otros ratones para detectarlo.
En un nuevo trabajo, que se publicará próximamente, Kimball observó cetonas específicas en la orina humana durante las primeras horas tras una conmoción cerebral. La razón por la que se liberan estos olores tras tales lesiones no está clara, pero una teoría es que el cerebro libera COV como subproducto mientras intenta repararse a sí mismo.
“La clase de cetonas que observamos sugiere que tiene algo que ver con intentar proporcionar más energía al cerebro para combatir la lesión, o al menos favorecer la recuperación”, afirma Kimball.
Hay buenas razones para pensar así. Los estudios han demostrado que las cetonas pueden servir como fuentes de energía alternativas tras una lesión cerebral y se cree que proporcionan cualidades neuroprotectoras.
El olor corporal también podría revelar que alguien tiene malaria. En 2018, científicos descubrieron que los niños infectados con esta enfermedad desprenden un olor distintivo a través de la piel, lo que los hace especialmente atractivos para los mosquitos.
Al estudiar muestras de 56 niños del oeste de Kenia, el equipo identificó un olor “afrutado y herbáceo” que parecía irresistible para los insectos voladores y picadores.
Un análisis más detallado de estas muestras reveló la presencia de sustancias químicas llamadas aldehídos, concretamente heptanal, octanal y nonanal, responsables de ese olor único.
La investigación podría utilizarse para desarrollar una nueva prueba para la malaria. Por ahora, los científicos esperan replicar el olor y utilizarlo como cebo para atrapar mosquitos, alejándolos de las comunidades y aldeas.
Y Mershin, un antiguo investigador científico del MIT que ahora trabaja en RealNose.ai, afirma que él y su equipo esperan desarrollar un dispositivo de detección de olores capaz de identificar el cáncer de próstata, una enfermedad que mata a uno de cada 44 hombres.
“La empresa surgió de unos 19 años de investigación que realicé en el MIT, donde Darpa [la Agencia de Proyectos de Investigación Avanzada de Defensa] me pidió que superara la capacidad olfativa de los perros en cuanto al límite de detección”, explica Mershin. “Básicamente, nos pidieron que creáramos biocyborgs“.
Dispositivo
El dispositivo que está desarrollando actualmente RealNose.ai incorpora receptores olfativos humanos reales, cultivados a partir de células madre en el laboratorio, que se ajustan con precisión para permitirles detectar la gran cantidad de moléculas odoríferas asociadas al cáncer de próstata. A continuación, el aprendizaje automático, una forma de inteligencia artificial, busca patrones en la activación de los receptores.
“No alcanza con conocer los componentes de lo que hay dentro de una muestra”, afirma Mershin. “Los ingredientes de un pastel nos dicen poco sobre su sabor o su olor. Eso tiene que suceder después de que tus sensores interactúen con estos compuestos volátiles y tu cerebro procese esa información y la convierta en una experiencia perceptiva.
“Buscamos patrones en la activación sensorial que se acerquen más a lo que hace la mente, el cerebro”, explica Mershin. Joy, por su parte, trabaja ahora junto a Barran en su equipo de investigación, ayudándola a desarrollar una prueba de diagnóstico para el Parkinson y otras enfermedades.

“Ya no la utilizamos mucho para la detección de olores”, afirma Barran. “Como mucho, puede analizar 10 muestras al día y es bastante agotador emocionalmente para ella. Tiene 75 años, así que es muy valiosa”.
No obstante, si la técnica de Barran pudiera replicar la capacidad de Joy y detectar la enfermedad de Parkinson en sus primeras etapas, sería un gran legado para Joy y Les.
“Lo que me parece notable es que Joy y Les eran personas con formación médica, por lo que sabían que esta observación era significativa”, comenta Barran. “Pero creo que la moraleja de esta historia es que todo el mundo debería sentirse capacitado para cuidar de su salud o la de sus amigos o familiares, para hacer observaciones y actuar si cree que algo va mal”.
Otras noticias de Salud
1La nueva serie de Netflix para maratonear sin culpa: tiene siete capítulos y te atrapa desde el primer segundo
- 2
Horario del GP de Abu Dhabi de la Fórmula 1 2025, con Franco Colapinto
3Mortal choque frontal en el comienzo del fin de semana largo
- 4
Inter Miami campeón: ganó 3-1 a Vancouver Whitecaps y se quedó con su primera MLS Cup









